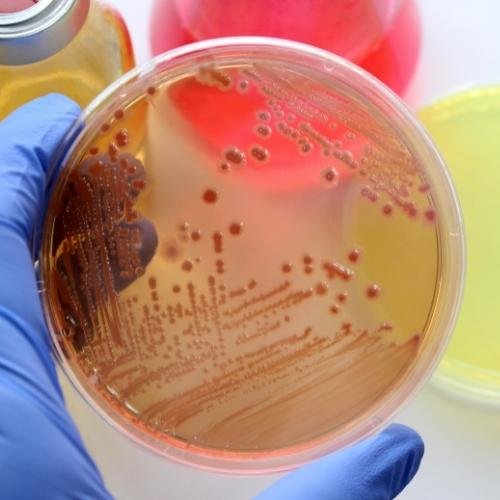

⭐⭐⭐⭐⭐
“Los análisis químicos fueron muy precisos y rápidos, nos ayudaron a cumplir con la normativa.”
En EAM Industrial brindamos una amplia gama de análisis químicos industriales que garantizan la calidad, seguridad y cumplimiento normativo en distintos sectores.
En EAM Industrial ofrecemos consultorías especializadas en procesos químicos e industriales, orientadas a optimizar la eficiencia, garantizar el cumplimiento normativo y reducir riesgos operativos.
En EAM Industrial contamos con equipos y materiales especializados para el control y monitoreo de procesos industriales y de laboratorio.
25 Años Transformando la Industria Química
Somos una empresa costarricense liderada por un Ingeniero Químico-Industrial con más de 25 años de experiencia. Nos especializamos en análisis químicos de alta precisión, venta de equipos de medición de última tecnología y consultorías profesionales que generan soluciones reales para la industria.
Más de 25 años de experiencia
Clientes satisfechos
Consultorías completadas
En EAM Industrial realizamos análisis químicos industriales, ofrecemos consultorías especializadas y suministramos equipos de medición confiables.
En EAM Industrial brindamos una amplia gama de análisis químicos industriales que garantizan la calidad, seguridad y cumplimiento normativo en distintos sectores.
En EAM Industrial ofrecemos consultorías especializadas en procesos químicos e industriales, orientadas a optimizar la eficiencia, garantizar el cumplimiento normativo y reducir riesgos operativos.
En EAM Industrial contamos con equipos y materiales especializados para el control y monitoreo de procesos industriales y de laboratorio.

La experiencia y confianza que su industria necesita
En EAM Industrial entendemos los retos que enfrentan las industrias al momento de garantizar la calidad, seguridad y cumplimiento en sus procesos. Con más de 25 años de experiencia en ingeniería química, brindamos soluciones confiables a través de análisis especializados, consultorías estratégicas y equipos de medición de alta precisión. Nuestro compromiso es acompañar a cada cliente con un servicio integral y resultados que generan valor real para su operación.
⭐⭐⭐⭐⭐
“Los análisis químicos fueron muy precisos y rápidos, nos ayudaron a cumplir con la normativa.”

⭐⭐⭐⭐⭐
“Excelente servicio de consultoría, logramos optimizar varios procesos de producción.”

⭐⭐⭐⭐⭐
“Los equipos de medición que adquirimos son de gran calidad y fáciles de usar.”

⭐⭐⭐⭐⭐
“Muy profesionales, explican cada resultado de forma clara y confiable.”

⭐⭐⭐⭐⭐
“Gracias a sus análisis de aguas pudimos mejorar nuestro sistema de tratamiento.”
⭐⭐⭐⭐⭐
“Un aliado estratégico para nuestra empresa, siempre atentos y responsables.”

⭐⭐⭐⭐⭐
“Equipo serio y con gran experiencia, se nota en la calidad del trabajo.”

⭐⭐⭐⭐⭐
“La consultoría fue clave para reducir costos y elevar la eficiencia.”

⭐⭐⭐⭐⭐
“Los recomiendo totalmente, resultados confiables y excelente atención al cliente.”

Su proyecto merece soluciones confiables
En EAM Industrial estamos listos para acompañarle con análisis químicos de precisión, consultorías especializadas y equipos industriales de calidad. Contáctenos hoy y dé el siguiente paso hacia procesos más seguros y eficientes.
CR: +506 7222-5500